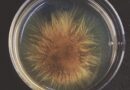
Population Bottlenecks Shape the Evolution of Cooperation in Bacterial Societies - IISc Study

भारतीय पशु चिकित्सा अनुसंधान संस्थान बनेगा ओडिशा राज्य के लिए ‘नॉलेज पार्टनर’
पशुधन क्षेत्र के विकास हेतु दीर्घकालिक सहयोग प्रस्ताव
बरेली | CampusKatta News | 7 जनवरी 2026
भाकृअनुप–भारतीय पशु चिकित्सा अनुसंधान संस्थान (आईवीआरआई), इज्जतनगर द्वारा “पशु स्वास्थ्य एवं उत्पादन में नवीन प्रगति” विषय पर ओडिशा राज्य के पशु चिकित्सा अधिकारियों के साथ एक दिवसीय इंटरफेस बैठक का आयोजन किया गया। यह कार्यक्रम हाइब्रिड मोड में आयोजित हुआ, जिसमें ओडिशा राज्य के पशु चिकित्सा अधिकारी, आईवीआरआई के वैज्ञानिक, अधिकारी एवं विद्यार्थी सहित कुल 502 प्रतिभागियों ने सहभागिता की।
ओडिशा सरकार–आईवीआरआई के बीच दीर्घकालिक साझेदारी का प्रस्ताव
कार्यक्रम के मुख्य अतिथि श्री सुरेश कुमार वशिष्ठ, आईएएस, प्रमुख सचिव, मत्स्य एवं पशुपालन संसाधन विकास (ARD) विभाग, ओडिशा सरकार ने कहा कि आईवीआरआई को ओडिशा राज्य के लिए “नॉलेज पार्टनर” के रूप में कार्य करना चाहिए। उन्होंने वैक्सीन विकास, गुणवत्ता मूल्यांकन (Quality Assessment) तथा पशुधन आधारित उद्यमिता को बढ़ावा देने के लिए मज़बूत और दीर्घकालिक सहयोग की आवश्यकता पर बल दिया।
उन्होंने कहा कि आईवीआरआई की वैज्ञानिक विशेषज्ञता, अनुसंधान क्षमता एवं तकनीकी नवाचार ओडिशा के पशुधन क्षेत्र के समग्र विकास, किसानों की आय में वृद्धि और रोजगार सृजन में महत्वपूर्ण भूमिका निभा सकते हैं।

‘विकसित ओडिशा–2036’ विज़न में पशुधन क्षेत्र की अहम भूमिका
विशिष्ट अतिथि श्री विजय अमृता कुलांगे, आईएएस, निदेशक, पशुपालन एवं पशु चिकित्सा सेवाएं, ओडिशा सरकार ने आईवीआरआई की पहलों की सराहना करते हुए राज्य सरकार के “विकसित ओडिशा–2036” विज़न को रेखांकित किया।
उन्होंने डेयरी, पोल्ट्री, सुअर पालन, बकरी पालन एवं संबद्ध क्षेत्रों पर राज्य सरकार के विशेष फोकस की जानकारी दी तथा VOTI प्रशिक्षण कार्यक्रमों और तकनीक हस्तांतरण के माध्यम से आईवीआरआई के साथ सतत समन्वय की आवश्यकता बताई।
आईवीआरआई की अनुसंधान क्षमताओं का विस्तृत प्रस्तुतीकरण
कार्यक्रम की अध्यक्षता करते हुए डॉ. त्रिवेणी दत्त, निदेशक-सह-कुलपति, आईवीआरआई ने संस्थान की पशु स्वास्थ्य एवं उत्पादन से जुड़ी अनुसंधान सुविधाओं, जैविक उत्पादों की गुणवत्ता जांच, रोग प्रकोप जांच, नस्ल संरक्षण, तकनीक हस्तांतरण एवं विस्तार गतिविधियों की जानकारी दी।
उन्होंने बताया कि आईवीआरआई को हाल ही में यूजीसी द्वारा नैक (A++) ग्रेड प्रदान किया गया है, जो शिक्षण, अनुसंधान एवं विस्तार कार्यों में संस्थान की उत्कृष्टता को दर्शाता है।

पशुधन क्षेत्र की प्रमुख चुनौतियों और तकनीकी समाधान पर चर्चा
स्वागत संबोधन में डॉ. रूपसी तिवारी, संयुक्त निदेशक (प्रसार शिक्षा), आईवीआरआई ने ओडिशा राज्य के साथ चल रहे प्रशिक्षण कार्यक्रमों की जानकारी दी। बैठक में ओडिशा के पशुधन क्षेत्र से जुड़ी प्रमुख चुनौतियों जैसे—
- प्रजनन संबंधी समस्याएं
- गुणवत्तापूर्ण चारे की कमी
- चयापचयी रोग
- बाह्य एवं रक्त परजीवी रोग
पर विस्तार से चर्चा की गई।
इसके साथ ही एफएमडी, एलएसडी एवं पॉक्स रोगों का स्ट्रेन विश्लेषण, जूनोटिक निगरानी (One Health Approach), एएमआर प्रबंधन, एआई आधारित पशु स्वास्थ्य उपकरण, टेली-वेटरिनरी सेवाएं, कम लागत डायग्नोस्टिक किट एवं वैक्सीन विकास जैसे विषयों पर विशेष मंथन हुआ।
उद्घाटन सत्र एवं समापन
उद्घाटन सत्र में मुख्य अतिथि के रूप में श्री सुरेश कुमार वशिष्ठ, आईएएस, विशिष्ट अतिथि श्री विजय अमृता कुलांगे, आईएएस तथा अध्यक्षता डॉ. त्रिवेणी दत्त ने की। कार्यक्रम में आईवीआरआई के वरिष्ठ अधिकारी, वैज्ञानिक, कर्मचारी एवं विद्यार्थी बड़ी संख्या में उपस्थित रहे।
कार्यक्रम का समापन डॉ. त्रिवेणी दत्त के समापन संबोधन से हुआ, जबकि डॉ. रोहित कुमार, वैज्ञानिक एवं कार्यक्रम समन्वयक ने धन्यवाद प्रस्ताव प्रस्तुत किया।